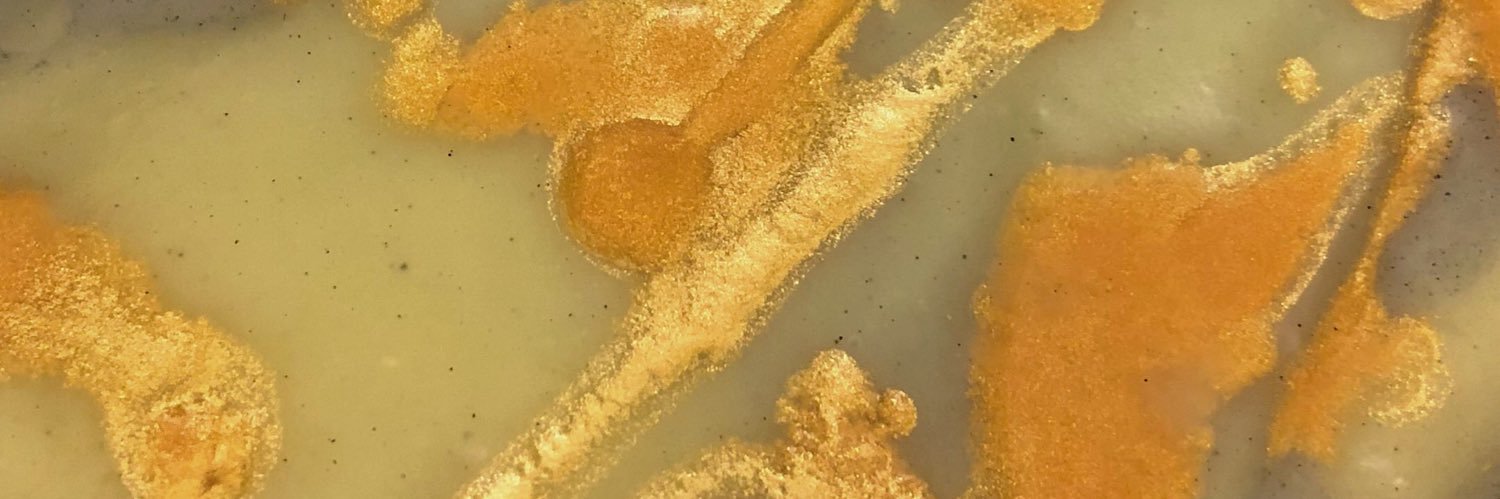
BAD MOUTH SOAP banner

Sabitlenmiş Tweet

🥳 Missed our 5 year celebration? That’s ok... Here is a great article on us to keep you up to date: thechronicleherald.ca/community/hali…
#badmouthsoap #soapforfilthypeople @chronicleherald
English
BAD MOUTH SOAP
2.5K posts

@BADMOUTHSOAP
|| Soap for Filthy People || Simple - Handmade - Clean ||































